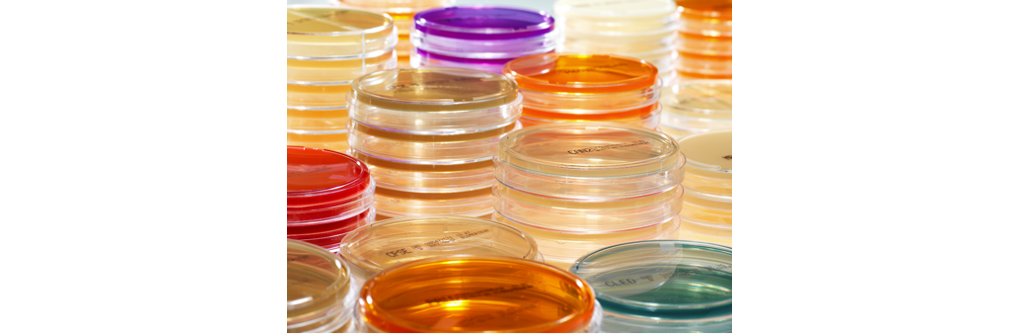

Understanding Bacterial Infections and Antimicrobial Resistance (AMR)
Harmful bacteria enter the body and multiply, leading to bacterial infections. These infections can occur in different parts of the body and range in severity from easily treatable to life-threatening.
When determining an appropriate treatment plan for a patient, it is imperative that a physician can accurately identify the causative pathogen to determine whether an infection is bacterial or viral. Traditional testing methods are often slow, and a physician might prescribe antibiotics empirically while awaiting results – particularly in high-risk cases such as instances of suspected meningitis and sepsis. If the infection is viral, antibiotics should never be used. It is important to note that empiric prescribing can contribute to unnecessary antibiotic use or overuse which is the main driver for the growing pandemic of antimicrobial resistance (AMR).1
Bacterial infections can be treated with antibiotics, specifically designed to kill or inhibit the growth of bacteria. Antibiotics work by targeting bacterial cell structures or functions. Antibiotic resistance continues to emerge, and some bacterial strains may be resistant to certain antibiotics making them more difficult to treat. One way to mitigate the emergence of AMR is through initiatives that support the appropriate use of antimicrobials such as Antimicrobial Stewardship Programs (ASPs).
Optimizing antibiotic use is critical to preserve use now and in the future, effectively treat infections, and combat AMR.2 The symptoms of bacterial infections can vary, and laboratory tests are needed to determine the specific cause of an infection. bioMérieux solutions equip the microbiology laboratory with the diagnostic tools needed to accurately identify the patient’s cause of infection.
Bacterial Infections – Our Diagnostic Offer
bioMérieux is a world leader in microbiology and for over 60 years has been providing labs worldwide with a wide range of manual and automated products as well as services and solutions to detect and identify bacterial infections.
Our diagnostic offer for bacterial infections is designed to support medical decisions in your institution to:
- Ensure optimal patient outcomes and avoid unnecessary antibiotic use
- Select the most appropriate treatment
- Personalize treatment duration to limit use of broad-spectrum antibiotics, avoid adverse side effects and discontinue antibiotics as early as possible
Disclaimer: Product availability varies by country. Please consult your local bioMérieux representative for product availability in your country.
-
BACT/ALERT® Culture Media Bottles
Innovative & Optimized Culture Media
BACT/ALERT® culture media offers a comprehensive range of media bottles to ensure the recovery of a wide variety of microorganisms including bacteria, mycobacteria, and fungi – including our next generation Fastidious Antimicrobial Neutralization Plus media (FAN® PLUS) offering optimized time to detection and recovery.
-
PREVI® COLOR GRAM
A Market-Leading Automated Gram Stainer Offering Confidence in Results
Gram staining is a key step in your microbiology workflow, and PREVI® COLOR GRAM is the system to streamline it and provide timely staining results for impactful decisions.
Culture strongly contributes to the quality and reliability of microbiology results for better patient management. For example, a direct MDRO and identification medium for correct patient isolation, ensures prompt adherence to HAI guidelines to prevent MDRO spread. Additionally, if you employ isolation and identification media specifically tailored for major pathogens, you can adjust treatment instead of conducting a full AST.
bioMérieux provides the largest ready-to-use chromogenic media to help labs in their daily practices, quality, and operations management. CHROMID® media are state-of-the-art media for better specificity, sensitivity, and recovery of most clinical pathogens.
-
Conventional Media
An extensive range of high quality, cost-effective conventional agar culture media
Put your confidence in bioMérieux, with High-Quality Culture Media Backed by 60+ Years of Leadership and expertise.
-
WASP®
Automated Microbiology Specimen Processing Instrument
Quality diagnostic results depend on high standard specimen processing. WASP® is the smart solution for truly comprehensive automation – taking you far beyond plating and streaking to address all aspects of microbiology specimen processing.
WASP® System is manufactured by COPAN Company. -
WASPLab®
Integrated Lab Optimization and Automation
The flexible automated specimen processing, incubation, and reading solution that adapts to your unique lab setup and workflow – and even grows with you over time.
WASPLab® System is manufactured by COPAN Company.
Differentiate, confirm, and identify microorganisms with confidence to provide fast, accurate results and support your antimicrobial stewardship goals.
-
VITEK® MS PRIME
New-Generation Mass Spectrometry Microbial Identification System
VITEK® MS PRIME combines microbiology expertise with innovation taking mass spectrometry to the next level by maximizing the impact of daily laboratory workflow for better patient care.
Of all the laboratory examinations performed daily by clinical microbiologists, antimicrobial susceptibility testing is of particular clinical importance. AST is a critical aid for selecting the most appropriate antimicrobial therapy for individual patients, monitoring the evolution of microbial resistance, and updating empirical therapeutic strategies.
-
VITEK® 2
Fully integrated Identification and Antimicrobial Susceptibility Testing
VITEK® 2, the leading automated system for routine antimicrobial susceptibility testing, provides efficient workflow, faster AST results. Its fully-integrated ID & AST approach ensures superior performance to rapidly and confidently guide therapy.
-
ETEST®
Antibiotic Susceptibility Testing Reagent Strips to Determine On-Scale MICs
Clinicians often need more information than what primary AST can provide. Recognized around the world for their proven performance, ETEST® ready to use reagent strips determine on-scale MICs.
-
VITEK® REVEAL™
Fast Antimicrobial Susceptibility Testing (AST) for Bloodstream Infections
The newest addition to our Sepsis Solution, VITEK® REVEAL™ offers fast AST results to effectively and efficiently manage bloodstream infections.
Syndromic infectious disease diagnostics using BIOFIRE® Panels can help take the guesswork out of pathogen identification. Syndromic testing combines several potential targets into one rapid diagnostic test. Fast sample-to-answer turnaround combined with comprehensive menus helps inform timely optimal therapy.
-
BIOFIRE® FILMARRAY® TORCH
Easier testing. Faster results.
Syndromic infectious disease testing with BIOFIRE® FILMARRAY® TORCH is the fastest way to better results.
-
BIOFIRE® Joint Infection (JI) Panel
1 Test. 39 Targets. ~1 Hour.
Using PCR technology, the BIOFIRE JI Panel is a rapid syndromic test that delivers comprehensive results in one easy-to-read report.
-
BIOFIRE® Blood Culture Identification 2 (BCID2) Panel
1 Test. 43 Targets. ~1 Hour.
The BIOFIRE BCID2 Panel tests for 43 targets associated with bloodstream infections, including Gram-negative bacteria, Gram-positive bacteria, yeast, and 10 antimicrobial resistance genes – all with one test and with results available in about an hour from positive blood culture.
-
BIOFIRE® FILMARRAY® Pneumonia & Pneumonia plus Panels
1 Test. Up to 34 Targets. ~1 Hour.
Syndromic tests targeting a comprehensive menu of bacteria and viruses that cause pneumonia and other lower respiratory tract infections, as well as 7 genetic markers of antibiotic resistance.
-
BIOFIRE® FILMARRAY® Meningitis/Encephalitis Panel
1 Test. 14 Targets. ~1 Hour.
The BIOFIRE ME Panel provides answers on 14 of the most common bacterial, viral, and yeast pathogens that cause central nervous system infections to help healthcare providers rapidly distinguish between bacterial and viral meningitis and optimize life-saving therapy.
-
BIOFIRE® FILMARRAY® Gastrointestinal (GI) Panels
1 Test. 11 or 22 Targets. ~1 Hour
BIOFIRE FILMARRAY GI Panels are fast and sensitive molecular stool testing methods for infectious gastrointestinal disease.
BIOFIRE® FILMARRAY® Gastrointestinal (GI) Panel tests for 22 targets from one patient sample. Its comprehensive menu includes 13 bacteria, 5 viruses and 4 parasites commonly associated with infectious gastroenteritis.
BIOFIRE® FILMARRAY® Gastrointestinal (GI) Panel Mid tests for 11 targets and offers clinicians another GI testing option. Its menu includes 7 bacteria, 1 virus and 3 parasites associated with infectious gastroenteritis. -
BIOFIRE® Respiratory 2.1 (RP2.1) Panel & Respiratory 2.1 plus (RP2.1plus) Panel
1 Test. Up to 23 Targets. ~45 Minutes.
The BIOFIRE RP2.1 and RP2.1plus Panels use the syndromic approach to accurately detect and identify the pathogens most associated with respiratory infections. Fast and comprehensive results may enable better-informed diagnosis and treatment of patients.
-
MAESTRIA™
New Generation Microbiology Middleware
An innovative, integrated software solution designed to orchestrate your lab routine and transform data into actionable insights.
Useful Resources for Bacterial Infection Diagnostics
References:
1. Dadgostar P. Antimicrobial Resistance: Implications and Costs. Infection and Drug Resistance. 2019;12(12):3903-3910. doi: https://doi.org/10.2147/idr.s234610
2. CDC. Core elements of hospital antibiotic stewardship programs. Centers for Disease Control and Prevention. Published 2019. https://www.cdc.gov/antibiotic-use/hcp/core-elements/hospital.html